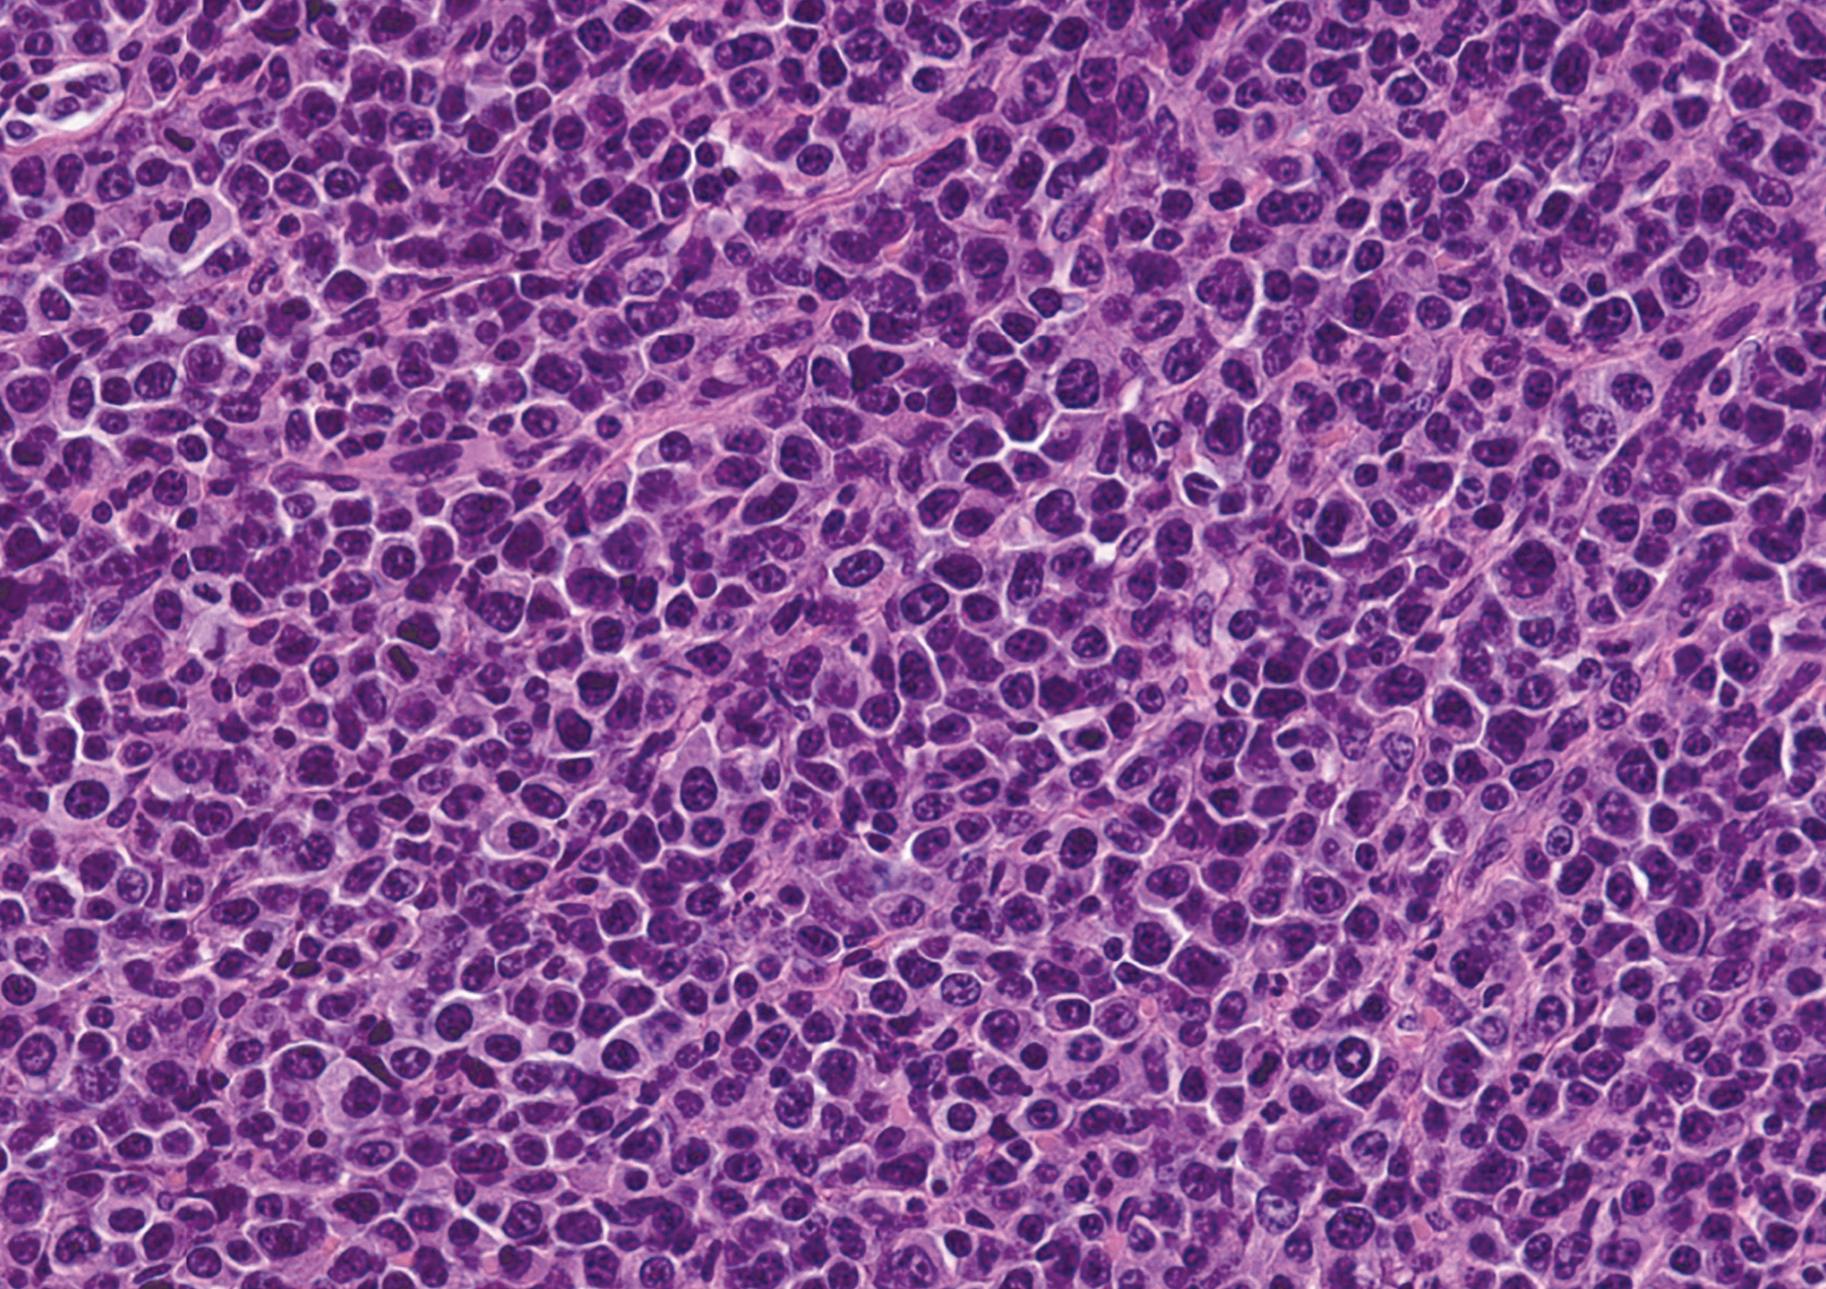

Spring Recruitment
Te Sun will be hosting our final info session today at 5 p.m. at Klarman Hall KG-42.

Spring Recruitment
Te Sun will be hosting our final info session today at 5 p.m. at Klarman Hall KG-42.
Cornell returned ancestral remains and funerary objects that had been kept in a University archive for six decades to the Oneida Indian Nation on Tuesday. President Martha Pollack apologized for the harm caused by this wrongful possession at a small Sage Chapel ceremony.

“We’re returning ancestral remains and possessions that we now recognize never should have been taken, never should have come to Cornell and never should have been kept here,” Pollack said at the ceremony.
According to a Notice of Inventory by the National Park Service available in the Federal Register, the remains were first found in August 1964. Local authorities were alerted when the remains
were unearthed during the digging of a waterline ditch near an Oneida village at Onaquaga in Broome County, N.Y.
Prof. Kenneth Kennedy, anthropology, was then asked to provide a forensic identification of the remains, which he completed by Sept. 8, 1964, determining that the human remains belonged to a young adult male of Native American ancestry. While it is unclear if the human remains were transferred directly to Kennedy’s laboratory or held temporarily by the Old Onaquaga Historical Society, correspondence between the president of OOHS and Kennedy confirms that an agreement was reached to house the remains at Cornell, according to the notice of inventory.
In 1990, Congress passed the Native American Grave Protection and Repatriation Act which provides guidelines for
the repatriation and disposition of certain Native American human remains, funerary objects, sacred objects and objects of cultural patrimony. NAGPRA also required institutions with prior possession of Native American human remains to report them to the federal government.
Tese remains, however, were unreported until Kennedy’s death in 2014. Te remains were then transferred to the Department of Anthropology where it was discovered that Kennedy’s original description of the human remains found did not note the presence of additional skeletal remains. Tese remains belonged to a child under four years old and a teenager under 20 years old. Due to their approximate age, their sex could not be determined.
Cornell eateries on campus aim to minimize food waste as part of the University’s larger sustainability initiatives. Student employees, Cornell Dining and student organizations exercise multifaceted efforts to reduce the waste of food in dining halls and redistribute food to the local community.

“We have multiple programs in place to minimize throwing away ‘ready-toeat’ food, both because we don't want

to waste food and because we don't want to waste funds, which comes down to students' funds,” said Karen Brown, senior director of campus life marketing and communications. Prepared food and bakery items at retail eateries get consolidated each Friday and redistributed to campus eateries open over the weekend. Tis allows for students to purchase these leftover items on the weekends, preventing them from being disposed of.
See WASTE page 3


The Industrial and Labor Relations School launched their Climate Jobs Institute on Jan. 25. The Institute will help New York state transition to a stronger clean energy economy by addressing the climate crisis and creating more jobs through continued cutting-edge research.
“There are two main objectives. We are trying to be a resource to labor unions around issues of climate change and the transition to clean energy,” said Lara Skinner, executive director of CJI. “[We
also want to be] a resource to elected leaders, legislators, policymakers and the city and state government who are also trying to figure these issues out.”
CJI will focus on conducting research, developing policies for governments nationwide to fight climate change and create union jobs, according to their website.
“We are the kind of people who look at all three of these things together and say ‘wait there’s a way to address all of these things at once, right?’” Skinner said. “We have to address climate change, and we have to do it at the pace and scale that science
demands, but also… We better be addressing inequality at the same time and making sure that we are righting historic wrongs as we build out this new economy.”
According to Skinner, after Hurricane Sandy, she saw firsthand how climate change has deeply impacted workers. She found it was time to create environmental movements in ways to handle climate change.
To continue reading this article, please visit www.cornellsun.com

Thursday, February 23, 2023

Today
Scaling-up Nature-based Solutions in Latin America
9 a.m., Willard Straight Hall, Memorial Room
Afghan Advocacy Event
11:15 a.m. - 12:15 p.m., Room 276 - Judge Henry W. Edgerton Classroom - Myron Taylor Hall
Traveling on the Underground Railroad w/ Prof. Gerard Aching (Black History Month)
11:30 a.m. - 1 p.m., 301 Sage Hall
Soup and Hope Speaker Series: Nik Pasqualini Noon - 12:45 p.m., Sage Chapel
Honoring Black History Through Collaboration and Celebration
12:15 p.m. - 1:30 p.m., Virtual Event
New York State Water Research Institute 2023 Spring Speaker Series: Applied Water Research in New York State
1 p.m. - 2:15 p.m., Virtual Event
Capturing Carbon: Nature-based Solutions to the Climate Crisis
2 p.m. - 3:30 p.m., Virtual Event

So You Want to Go to Graduate School
4:30 p.m. - 6 p.m., Virtual Event
Queer Black History Month Paint and Sip
5 p.m. - 8 p.m., 626 Thurston Room 106
Leadership Workshop: Inclusive Language Workshop
5:30 p.m. - 6:30 p.m., Virtual Event
Spam Musubi Making
6 p.m. - 7 p.m., Uris Hall 302


Getting Into Undergraduate Research
7 p.m. - 8 p.m., Tatkon Center (RPCC 101)
The University dining services also donates perishable food to the Food Bank of the Southern Tier a few times throughout the semester from residential dining rooms and from the catering kitchen.
More frequently, Cornell donates leftover food to the Food Recovery Network.
Despite February break’s short duration, many Cornell students have elaborate plans for the long weekend ahead, including touring new cities, enjoying time at home or catching up with friends and family.

About 44.8 percent of Cornell students hail from the tri-state area, making home easily accessible during short breaks. While most students who live abroad or across the country may not have the time or resources to return home, many are planning to visit American cities instead of staying on campus.
Students have plans for a fun, rejuvenating break as they hope to find comfort in places other than home or campus.
Originally from Westchester, Sydney Lonker ’25 plans to embark on a spontaneous road trip with her hometown friends.
“The plan is to go with no plan,” Lonker said.
After a laborious first month of the semester, Lonker hopes to take her mind off of academics and enjoy the open road.
“We are thinking of driving through Virginia and enjoying the coast or just hopping over the border to Canada,” Lonker said. “We go where the road takes us.”
Sia Harisingani ’26 is going to Chicago to visit her high school best friend, who attends Northwestern University. She looks forward to bonding with her best friend whilst remedying her second-semester restlessness.
Harisingani’s extensive itinerary includes attending a ceramics studio, sightseeing at The Bean and eating at a viral crepe cafe.
“I have all our restaurants and events scheduled,” Harisingani said. “Having seen each other every day for ten years, I mainly want to spend time with her. I miss her so much.”
Abigail Conrad ’26 and Sophia Landy ’26, who are native to California and Florida respectively, are renting an AirBnB in New Jersey to spend a few days exploring New York City. Neither of them have visited before.
“[I’m excited to] shop, go to museums and eat lots of Chinese food and other ethnic foods,” Landy said.
Conrad, having bought her Thanksgiving meal at the Ithaca Trader Joe’s, was determined to coordinate lively plans for this upcoming break.
“I’m just excited to take a break from school work and have a fun weekend with friends doing touristy things,” Conrad said.
Taking advantage of the opportunity to venture away from Ithaca, Landy appreciates the cheaper alternative of staying in the tri-state area.
“It’s just too expensive to fly home, and I’ve been dying to get off campus,” Landy said.
While some students are fully booked this February break, others plan to enjoy a more relaxing few days away from campus, like Rory Paltridge ’26, who is returning to New York City to spend quality time exploring his hometown with family and friends. He plans to meet up with Landy and Conrad.
“I’m excited to hang out with my little brothers and dogs, and show my friends around the city,” Paltridge said.
“They were put into the hands of institutions that would treat them as no more than museum items, merely of historical curiosity.”
No individuals were identified and 22 associated funerary objects were also recovered.
“I don’t want to single out Prof. Kennedy or anyone else in this case, but I think it’s fair to say that the archeologists and others now in our programs would not treat remains in the way they were treated in the past,” said Prof. Frederic Gleach, anthropology, in a statement to The Sun. “We are all committed to working respectfully and equitably with Native and other communities, and within the legal frameworks, including NAGPRA.”
Oneida Indian Nation representative Ray Halbritter attended Tuesday’s ceremony to speak about the importance of repatriation.
“The bodies of our ancestors, and the objects buried with them, were literally and unceremoniously removed from the Earth,” Halbritter said in his remarks at the ceremony.
The Indigenous Graduate Student Association released a statement to The Sun condemning the University for storing these remains.
“Cornell University administration must do a lot more than apologize and acknowledge,” the statement read. “This University is built on and with stolen Indigenous land and continues to hold other stolen Indigenous human remains.”
The IGSA is referring to a repatriation database generated by Propublica, which states that the University still has the remains of at least one Native American individual. However, this database has not been updated since Dec. 9.
According to Gleach, the process of repatriation under the current guidelines of the NAGPRA can be slow. Halbritter said the process may have been delayed.
“The return of our ancestors to our sacred homelands is a basic
human right,” Halbritter said. “It’s about our dignity. To delay their repatriation to us — presumably because admitting the wrongs was uncomfortable — is a continuation of the violations.”
Gleach defended the process in his statement to The Sun.
“The process of repatriation is often slowed by its very importance — that is, one wants to be sure it is done right, and not just done quickly,” Gleach said. “As in this case, and especially with older collections, it’s often complicated by having incomplete and sometimes incorrect information supplied with the materials, and by the complicated histories forced on indigenous communities by colonial policies and practices.”
According to Prof. Matthew Velasco, anthropology, the repatriation of the Oneida ancestors was the outcome of years of research and careful consultation with the tribal entities in central New York.
See REMAINS page 4
“Multiple days per week, the Food Recovery Network picks up prepared food that wasn’t set out on the line at our dining rooms or at catered events,” Brown said.
FRN is a nationwide non-profit with university chapters across the country, including at Cornell, that donate extra leftover food from dining halls to local food pantries. Surplus meals are currently donated to the Friendship Donations Network, which then redistributes food to different pantries across Tompkins County.
The non-profit works with Becker House, Cook House, Bethe House and Morrison Dining five times per week. Two to five volunteers go to the dining halls before closing and package the leftover food, and a driver then delivers the food to the FRN in Downtown Ithaca. FRN has also worked with local farms to collect and donate produce that will not be sold at the end of the season.
Cornell Hunger Relief serves as a student program that aims to combat food insecurity within Tompkins County. One of their biggest events, the Big Red Food Drive, occurs in May and allows students to use their remaining Big Red Bucks to purchase non-perishable food items. These items are then donated to the Friendship Donations Network.
“CHR donates all collected food items to Friendship Donations Network, a local hunger relief program that redistributes the donations to community members in need,” said Maria DiViovanni ’23, Cornell Hunger Relief co-president. “Last year, we had our biggest drive yet — over 4,500 pounds of food — and we look forward to keeping that momentum going this May.”
CHR is currently looking forward to their annual Future Food Summit in March, an open workshop which allows students to discuss and exchange information regarding our impact on food systems both on campus and in the greater community.
In the back of the dining halls, compost bins collect leftover food that cannot be saved. These bins are then combined with other compost materials and composted at Farm Services. The resulting compost mix is used by Cornell agricultural projects, used on campus for landscaping, donated to local organizations or publicly sold.
“Since we’re not permitted under the Health Department regulations to donate partial trays of prepared food that have already been set out for service, we compost the remnants, along with materials like unusable parts of vegetables trimmed in preparing meals, bones from cutting meat that’s to be cooked, lots and lots of coffee grounds, paper towels and other items that also end up in home compost bins,” Brown said.
On-campus dining employees such as Rina Hisajima ’24, a student manager at Alice Cook House, wishes more compost bins were available to students for their leftover food to be composted. However, dining employees have taken their own efforts to decrease food waste on campus.
“I have personally tried my best to mitigate food waste by being conscious of dropped food, but it was difficult,” Hisajima said. “Luckily, some of the student employees followed my example.”
The dining halls also monitor food waste with waste logs, allowing them to learn and adapt every week.
“Our managers do their best to order and prepare the right amount of food in their units. We’ve generally been seeing a decline in the numbers, with individual units curbing their waste,” Brown said. “We are continuing to work toward a campus where as much food as possible is eaten, rather than discarded because it can no longer be served.”
At the beginning of the pandemic, Cornell Dining partnered with the Food Bank of the Southern Tier and the Greater Ithaca Activities Center to create a food pantry resource available to the community. The food pantry served thousands of meals to the public, reallocating food from the closed eateries to the hands of Ithaca residents.
To continue reading this article, please visit www.cornellsun.com.
Business Manager Serena Huang ’24returned home and without further delay.”
Because the remains were rediscovered with little contextual information and because Kennedy’s correspondence related to the remains was rediscovered only during the Department of Anthropology’s archival research of Kennedy’s work, the process took a substantial amount of time to complete.
Despite this prolonged process, the Oneida Nation accepted the University’s efforts to return the remains to their rightful owners.
“We commend Cornell University for working with the Oneida Indian Nation to right this wrong,” Halbritter said. “You are confirming that the complexities of this process are worth solving and that the outcome is worth the time and cost required.”
To conclude the ceremony, Pollack and Halbritter each signed transfer documents.
“Our efforts to help bring the ancestors home cannot erase the harm done,” Velasco said in a statement to The Sun. “We are nonetheless humbled by the good will and generosity shown to us by our partners in the Oneida Indian Nation, and grateful that by working together, we were able to see that their ancestors were
However, the IGSA does not feel the University has done enough to address the many ways Cornell has interacted with Indigenous tribes.
“Repatriation is a political act,” the statement read. “Outside of positive PR, what will the University engage in to ensure accountability, redress and reparations?”
On Dec. 30, Governor Hochul vetoed an act that would have protected unmarked burials of Native Americans from being unintentionally excavated. The Morrill Act of 1862 distributed over 10 million acres of Native American land as a grant for the development of agricultural colleges, often taken through violence-backed treaties. Cornell was the largest beneficiary of the land-grant act.
“If dedicated to righting the wrongs, the IGSA demands the University put forth a statement condemning Governor Hochul [for] vetoing the Protection of Unmarked Graves Act, as well as a plan of action to address Cornell’s profiting of dispossessing Indigenous lands via the Morrill Act,” the IGSA said.
Throughout Black History Month, student groups are fostering community and intellectual development with events including a Love Island parody, cooking instruction, a professional retreat and a trip to Washington D.C.
Black History Month occurs annually to acknowledge Black history in the United States and to celebrate the accomplishments of Black Americans. All U.S. presidents have distinguished February as Black History Month since 1976.
“While we work towards a world where Black history is acknowledged and celebrated during all months, I see Black History Month as an opportunity to explore Black and African American struggle, joy and triumph,” said Obioha Chijioke ’24, co-president of Black Students United.
According to Chijioke, Black history is frequently censored in education, so it is important to memorialize those who have given their lives for Black advancement and those whose forced labor built the foundations of the U.S. Through Black History Month events, students can reconsider their misconceptions and ask questions surrounding Black culture and Black history.
Previously named Cornell’s Afro-American Society, the BSU is credited for occupying Willard Straight Hall in 1969 in reaction to several racially charged incidents at the University. Today, the BSU is an umbrella organization encompassing 29 cultural, mentorship, performance, professional and Greek organizations that uplift Black students.
For Black History Month event planning, the BSU established an overall theme of “Black 2 the Future” inspired by the concept of Afrofuturism — a movement envisioning a future where African-descended people and their cultures are valued. The BSU plans to facilitate events that foster unity and celebrate freedom while establishing safe places for constructive dialogue.
“In a time where Black history is under siege, ‘Black 2 the Future’ asserts that there must be space for Blackness to thrive in humanity’s collective future,” Chijioke said. “We’re also acknowledging how Blackness has already thrived in our past and pursuing Afrofuturism as a homage to the brilliant people [that came before us].”
According to Tofunmi Olabode ’24, co-president of the BSU and co-president of the Nigerian Students Association, the BSU emphasized collaboration among various affiliated groups throughout Black History Month event planning.
The NSA collaborated with Ghanaians at Cornell to host Love Island on the Hill, mimicking the popular dating reality show, Love Island.
working class and fighting climate change.
Olabode said that the event intended to celebrate diversity, which generally lacks within a show which emphasizes eurocentric beauty standards.
“Being that Love Island contestants are typically White, one of our students said that it would be nice to appeal to a different kind of beauty standard with Black contestants,” Olabode said. “[We thought that hosting a Love Island parody] would be a nice, fun way for us to enjoy [Love Island] within our community because a lot of its viewers are Black [and] are often rooting for the one Black couple there.”
The Caribbean Students’ Association collaborated with the Haitian Students Association to host a cooking workshop, teaching students how
“The New York State government’s plan was heavily influenced by Skinner’s report, and so we were getting traction on that, which is important as part of ILR’s mission,” said ILR School Dean Alexander Colvin Ph.D. ’99.
Through Skinner’s work from post Hurricane Sandy, an organization called Climate Jobs New York was launched to influence climate and jobs policy in New York State. Because of this model’s success, other climate job coalitions have been founded in eight other states. As the work grew, so did the need for an institution completely committed to research and policy development — leading to the establishment of the Climate Jobs Institute.
CJI’s primary academic and educational partner is the Climate Jobs National Resource Center. The CJNC aims to educate workers on climate change and build a more sustainable economy, fighting climate change, creating quality union jobs and building safer
“Thinking about it from a career development perspective, you don’t really need a degree to go be a union organizer or anything, but here I was at ILR,” Lamm said. “I wanted to still be able to help out, build the labor movement, make it more progressive, fight climate change and find a good balance between theoretical and practical advancement. I found that in [CJI].”
“This is also about economic development, and about making sure we’re strengthening our economy.”
Lara SkinnerOne of CJI’s main goals is creating new jobs by researching cities’ and states’ needs for addressing climate change, then building around that to reduce emissions and form new industries.
“This is also about economic development, and about making sure we’re strengthening our economy. …So then we’re looking at where the opportunities are to build a whole new industry,” Skinner said. “Maybe it’s people putting up offshore wind turbines, which is great work and really high-skilled work. But it’s also an opportunity to build a whole new manufacturing sector.”
and equitable communities.
Maine, Rhode Island, Texas and New York have all adopted plans and established policies by CJI for labor coalitions. In addition to continuing work in N.Y. CJI is developing agendas in Connecticut, Illinois, Massachusetts, Washington, Wisconsin, Maryland, California and Pennsylvania.
to make Caribbean delicacies on Monday.
Aliya Sweeney ’23, president of the CSA, said that they wanted to highlight fun aspects of Caribbean culture including their food and music.
“[We wanted to] make [Black students] feel at home, celebrate their culture, make them feel proud [and emphasize to them] what Black people have contributed to society,” Sweeney said. “But then [we] also [wanted] to educate students who may not know about [Caribbean culture]. Cornell is so diverse and there’s so many people who have probably never tried Haitian patties [for example].”
Les Femmes De Substance — which is focused on service, mentorship and professional development for women of color — attended their 16th Annual Women of Substance Retreat in Syracuse, NY from Friday, Feb. 3 to Sunday, Feb. 5.
According to Naana Owusu ’25, publicity chair of Les Femmes de Substance, the organization had the retreat planned for a while and thought it was extra powerful to hold it during Black History Month.
To continue reading this article, please visit www.cornellsun.com.
“We got state money to help us do this work [and] got to the point where we felt we were ready to stand this up as an institute,” Covin said. “It really had grown naturally into an institute, and we viewed it as a priority area for this school.”
ILR focuses heavily on reshaping the future of work, employment and labor, according to their website. As CJI works to develop a new, climate friendly economy, the courses and study in the ILR School will be modified to fit the institute’s progression.
“The shift to a climate friendly economy is a huge potential shift in the economy, and so that’s going to affect a lot of workers, a lot of labor,” Colvin said. “So it’s important for the [ILR] School to be studying issues like that.”
According to Research Support Specialist Nathan Lamm ’22, who recently graduated from the ILR school and found work at CJI, has enjoyed applying the knowledge he learned from ILR courses and working at a company that involves his two biggest professional interests — supporting the
Skinner emphasized the necessity of creating jobs with high wages, adequate benefits and safe work environments when building a sustainable economy.
“I think it’s one of those barriers to creating a climate-friendly economy — if people are scared for their jobs, and they [start to see] a green economy as a threat to them, I think that’s going to produce resistance,” Colvin said.
These new jobs are also centered around environmental justice communities, those most impacted by climate change and pollution. CJI wants to ensure these individuals are the ones to have these jobs. In doing this they build a new economy, a more fair one, providing equitable access to good jobs, according to Skinner.
“We really sort of hand over that policy to legislators and advocaters and say ‘here are our recommendations for how you best create jobs in the state,’” Skinner said.
According to Skinner, CJI will also conduct research on climate change’s impacts on labor and employment, including how rising temperatures and heat waves affect worker productivity.
“One thing I would highlight is we are doing the first ever study of working conditions in the New York solar industry,” Skinner said.
To continue reading this article, please visit www.cornellsun.com.
“It realy had grown naturally into an institute, and we viewed it as a priority area for this school. ”
Dean Alexander Colvin Ph.D. ’99
“[We wanted to] make [Black students] feel at home, celebrate their culture, make them feel proud [and emphasize to them] what Black people have contributed to society.”
Aliya Sweeney ’23
Campus afnity groups join forces to acknowledge BHM with various events

There is no question that a college student and caffeine remain a universally dynamic duo in which a whopping 92 percent of students have used in the past year, with an average consumption of 159 milligrams per day (about one and a half cups of coffee). Whether caffeine’s energy boost is used by students for waking up, studying or staying alert and focused with a “pick me up” or working out, there is a seemingly endless supply of products available on the shelves to feed the demand behind student consumption. One of these products — CELSIUS energy drinks — has recently been stimulating its way through the Cornell student body where it is becoming ever so common to see the signature white can and Celsius logo with the slogan “Live Fit” peeking out of the hands of students. Always within close reaching distance on desks and tables and in hand while walking to classes, these drinks have become a routine and reliable companion for many — as demonstrated by almost 100,000 Amazon reviews with a 4.7/5 star rating. But what exactly is so special about these drinks named after a unit of measurement for temperature and why are there so many? In fact, Cornell’s convenience stores such as Jansen’s Market and Bear Necessities have had a shockingly high supply of these drinks beginning this Spring 2023 semester, with boxes of drinks loaded on top of each other multiple
feet high and on center display to easily be purchased with BRBs or other payments. Here, we will dive further into the background of this energy drink that is rapidly gaining popularity and business on Cornell’s campus.



The website of CELSIUS coins the product as a “functional drink…completely vegan, free of carbohydrates, [and] containing only natural flavors and colors.” With a nutrition profile seemingly too good to be true, each 12 ounce can contains 200 milligrams

ically proven to boost your metabolism and help you burn body fat” in a wide variety of refreshing flavors such as Arctic Vibe Frozen Berry, Raspberry Acai Green Tea, Fuji Apple Pear and Tropical Vibe Starfruit Pineapple. However, there are some details that are not as transparent from a first glance at this company’s mission that may very well be juicier than the product flavors themselves.
CELSIUS marketing promo of which the conditions entail purchasing two 12 ounce CELSIUS cans for $5 to be entered into a drawing to win a kayak. Further directions of how to enter personal information to be notified of a winning were however left out of the flyer. Of all prizes available that could be helpful for a college student, a kayak is a strange choice —
of caffeine accompanied by the stimulating amino acid rine and along with other various vitamins. “Live Fit” — the company’s slogan — complies with the company’s mission that “When combined with exercise, our formula is clin-

There is currently a class action lawsuit being held against CELSIUS due to the words “Preservative Free” printed on the top of each can, despite the presence of citric acid in the ingredients. CELSIUS denies this accusation, claiming that citric acid is used as a flavoring instead of as a preservative. Anyone who has purchased a beverage from the company between Jan. 15, 2015 and Nov. 23, 2022 is eligible to be a class member and is entitled to receive a cash payment as long as potential members have submitted a valid claim by Feb. 13, 2023. With a $7.8 million total payout, those with valid claims can receive 1 dollar for every purchased can and $5 per package of purchased powder packs similar to the Gatorade and Liquid I.V. sticks. This chunk of change is of course not advantageous for CELSIUS to be responsible for, but could this settlement be the reason there are so many CELSIUS drinks recently being put up for sale in Cornell’s convenience stores?
While shopping for other goods from Bear Necessities, I coincidentally came upon a flyer for a related
maybe the lucky winner will be able to have a smooth ride during the rainy season, but this promo demonstrates even further incentive to purchase CELSIUS products.
In a seemingly contradictory fashion, CELSIUS seems to be running a
promo to purchase more drinks while simultaneously having to pay out customers who bought said drinks. Could it be an attempt to recover the $7.8 million being paid out in the class action? Or maybe a surplus of supply to meet the growing demand of energy drinks fueling Cornell students? It is quite possible this excessive surplus of drinks could have been mistakenly purchased from Cornell as well. While CELSIUS drinks and their nutrition labels may appear clean, health-oriented and energizing on shelves, a lot more is going on behind the scenes with this company’s class action lawsuit and marketing promotion. These factors very well could be related to the recent seemingly absurd surplus of drinks found in convenience stores across campus and the reason behind how these drinks have become so accessible and popular at Cornell. Despite being in a complicated and intriguing situation, these drinks are a hit in taking part to energize our student population and may be worth a try for those experienced with caffeine and looking for a new energy drink that is simpler and more effective.
Kyle Roth is a sophomore in the College of Human Ecology. He can be reached at ksr73@cornell.edu
There is currentlyaclass action lawsuitbeing heldagainst CELSIUS due to the words “Preservative Free.”
... a routine and reliable companion for many as demonstratedbyalmost 100,000 Amazon reviews with a 4.7/5 star rating
SERENA HUANG ’24
Business Manager
EMMA LEYNSE ’23
Associate Editor
SURITA BASU ’23
Assistant Managing Editor
NAOMI KOH ’23

Assistant Web Editor
ELI PALLRAND ’24

News Editor
ESTEE YI ’24
News Editor
KAYLA RIGGS ’24
City Editor
JULA NAGEL ’24
Photography Editor
MEHER BHATIA ’24
Science Editor
KATRIEN DE WAARD ’24
Production Editor
PAREESAY AFZAL ’24
Julia Gonzales ‘23 is a student in the College of Engineering and Brandon Restler ‘23 is a student in the College of Agriculture and Life Sciences. Comments can be sent to opinion-editor@cornellsun.com. Climate Justice Cornell can be reached at cjc.cornell@gmail.com. Amplify! runs alternate Wednesdays this semester.
Recently, I was reminded of the Cornell endowment fossil fuel divestment campaign when I cleaned old Climate Justice Cornell posters out of the cooperative house I live in. The house used to be a meeting place for CJC before I began living there in the fall of 2020. Now, as the two last Climate Justice Cornell members who took part in the first divestment campaign are about to graduate from the University, we want to share some of the history of the campaign and where CJC is turning its attention next.
divestment did happen, but may have happened anyway without all of the activism work of the past few years.
Still, the divestment campaign was not without its detractors — CJC members warned each other of the vague threat of Cornell surveilling our actions related to the divestment campaign.
MADELINE ROSENBERG ’23
Senior Editor
The divestment campaign began many semesters ago but notably gained momentum starting in the fall of 2019. CJC members reached out to faculty and students from other clubs, gaining support from a wide collection of allies ranging from Mothers Out Front, to Cornell University Sustainable Design, to the Vegan Club.
CJC and other clubs held public protests nearly every week during the spring of 2020 until the campus shut down due to COVID-19. The most notable of these was a mock wedding between Cornell and the fossil fuel industry — two puppets modeled after the clocktower and a Monopoly Man-esque fossil fuel executive were paraded around Ho Plaza by students in orange beanies and oilthemed masks. Other protests focused on the intersectional elements of the campaign such as migrant and racial justice, acknowledging that climate change is inherently a social justice issue.
New York State Attorney General Letitia James (D-N.Y.) sent us a letter saying that she refused to sue Cornell for negligence with its endowment after CJC sent a formal complaint to her office about Cornell’s willingness to invest in a dying fossil fuel industry. CUPD officers trailed us to and from protests. Even on the Cornell subreddit, anonymous users complained about some of our protest tactics like blocking campus roads and littering trees by Day Hall with streamers. Despite these setbacks, Cornell divested anyway.
CJC members warned each other of the vague threat of Cornell surveilling our actions related to the divestment campaign.
However, Cornell money continues to find its way into the fossil fuel industry through the Teachers Insurance Annuity Association, which provides retirement funds for all Cornell professors. With $1.3 trillion total in assets, the company currently has $78 billion invested in fossil fuels, and is the fourth largest holder of coal bonds in the world.
Furthermore, while it offers ESG (Environmental, Social, Governance) products, the so-called “low carbon” funds contain more fossil fuel investment than the general funds. It is clear that the company is green-washing and misleading its clients.
Both the Student Assembly and University Assembly stood in support of the campaign by passing resolutions calling on Cornell’s board of trustees to divest. Even Vice President for Student and Campus Life Ryan Lombardi was forced to address the situation when a group of 12 students hosted a sit-in outside Pres. Martha Pollack’s office, taking over the administrative offices on the third floor of Day Hall. Ultimately, the board announced a moratorium on new fossil fuel investments in May 2020. Or rather, we learned that the moratorium began several years ago when the board’s investment committee made the decision to divest secretly.
This was a bittersweet moment in that
Continuing its legacy of fighting for divestment, Climate Justice Cornell is joining forces with TIAA Divest, a campaign working to pressure TIAA to stop investing in fossil fuels. On Valentine’s Day, members distributed “divestmentines,” fliers aimed to spread awareness about the company’s actions among professors, many of whom are not even aware that their retirement funds are fueling climate destruction.
Immediate plans include emailing professors and potentially holding rallies and press conferences to draw attention to the issue. However, if that doesn’t work, CJC is prepared to support further actions to ensure Cornell upholds its alleged commitments to a clean future.

Fill in the empty cells, one number in each, so that each column, row, and region contains the numbers 1-9 exactly once. Each number in the solution therefore occurs only once in each of the three “directions,” hence the “single numbers” implied by the puzzle’s name. (Rules from wikipedia.org/wiki/ Sudoku)






We have availability for the 2023-2024 school year beginning June 1st at Hudson Heights apartments. These studios include electric, heat, water, garbage and parking. Coin-operated laundry facilities available on site. Prices start at $850/month for a 12 month lease, with options for 10 month leases with different rates. If you have any questions or would like to schedule a tour contact us by email: renting@ithacaLS.com. Please visit our website www.ithacalivingsolutions.com for photos and more information.
414 Stewart Ave. 4, 6, 8, 10, 14 Bedrooms Free parking & laundry. Large kitchens. Updated bathrooms. Sunny. Call or text 607-227-1923
1 Bedroom Apartment Downtown Available Aug. 1 (or as early as June 1) Ideal for grad, staff or working professional. Upstairs apartment with full bath, living room, kitchen, bedroom and porch overlooking street. Quiet downtown area on Cascadila St. Bus stop in front of house to Commons, then CU campus. No undergrads, no smokers, no pets. References required. $1025/mo plus util. Info or appointment: email gm27@cornell.edu
Mini Goldendoodles ready to go home at the end of March. 4 boys 6 girls available. Family raised, dewormed, first shotsm vest checked. AKC registered lines. $1800-$2000 585-626-8409
By KAITLIN CHUNG Sun Contributor
By KAITLIN CHUNG Sun Contributor
Researchers of the Melnick Lab, led by Prof. Ari Melnick, medicine, recently published a study identifying a key mutation that disrupts the B-cell natural selection process during immune response, leading to aggressive diffuse large B-cell lymphoma within the body.
DLBCL is a type of cancer found in the lymphatic system, which plays an important role in the body’s germ-fighting immune system. DLBCL can expand rapidly and is difficult to eliminate, with at least 40 percent of patients not responding to treatment.
The root cause for DLBCL lies within mutated B-cells, which are white blood cells that produce protective proteins called antibodies. Thousands of B-cells develop in a specialized structure of lymphoid organs called the germinal center, where they undergo a cyclical process of mutation and rapid growth.
B-cells compete for selection by a smaller number of T-cells — white blood cells that recognize foreign
particles called antigens. Selected B-cells then receive signals that enable them to differentiate and help initiate immune response.
The germinal center is one of the unique places in the body where intense competition between cells occurs, since most human tissues require cooperative and altruistic cell behavior to function. This volatile process leads to rapid accumulation of abnormal mutations.
According to Dr. Coraline Mlynarczyk, medicine, co-author of the study and research associate of the Melnick Lab, lymphomas arise because B-cells are subjected to high pressure to mutate, divide and be selected by T-cells. If mutations occur in unexpected locations, B-cells can gain abnormal survival advantage.
To identify the mechanisms behind B-cell growth, the researchers examined mutations in the B-cell translocation gene 1, which are found exclusively in aggressive B-cell tumors. This gene encodes for a checkpoint protein that governs B-cell natural selection and ensures that only a
few selected B-cells survive competition. It also controls the expression of MYC, a powerful regulator that fuels cell growth. The researchers found that in cells with BTG1 mutations, MYC expression is inappropriately enhanced.
“We looked at where genes are regulated by certain alterations in proteins to see how the B-cells changed. What we found is that mutant cells have an enriched version of MYC,” Mlynarczyk said. “It’s a subtle effect, but with every round of B-cell growth, the cells’ response becomes slightly faster, and over time, it becomes a big and aggressive lymphoma.”
Mlynarczyk and her team found that cells with BTG1 mutations respond faster to T-cell selection signals every cycle until they can outcompete other cells. The researchers studied this super-competition phenomenon in mice, which were created to express the same mutant form of BTG1 most frequently found in patients.
To achieve these results, the team collaborated with researchers from Rockefeller University and the Memorial Sloan Kettering
Cancer Center. The scientists at Rockefeller had deep expertise in the specifics of how immune responses work, and the teams at Cornell and MSKCC were focused on the biochemical mechanisms of the process, according to Melnick, the study’s senior author.
Looking back, Mlynarczyk and Melnick reflected on the difficulties and triumphs they faced for over two years working on
this research. Mlynarczyk noted that it was particularly challenging to understand the subtle effects of MYC enrichment.
The Melnick lab now aims to study the mechanistic pathways of checkpoint security, cell signaling and fitness acquisition to ultimately inform novel therapeutic strategies.
“Within all these different mechanisms that intersect with each other, you
begin to see a pattern. This complicated picture comes together to give you a feel for the biological mechanisms that have to be perverted to target the tumors,” Melnick said. “After the past couple of years, we’re now starting to see the puzzle, but there’s still a lot to learn to get to the ultimate medical goal — to cure the patients.”
The James Webb Telescope, a telescope which Cornell faculty helped build and develop, collects data from the furthest corners from our solar system, and Cornell faculty hope to use it to catch a glimpse into what lies beyond Earth.
The James Webb Telescope can analyze both visible and infrared wavelength spectrums. Because the Webb telescope is much
more sensitive than other telescopes like the Hubble telescope, it can see fainter objects in space. Many Cornell researchers are excited to see the data the James Webb Telescope can collect on these objects.
Cornell faculty are currently working with the telescope for various reasons, such as research on characterization of exoplanets or observation of gas giants and their stars. One of these faculty members is Prof. Jonathan Lunine, astronomy, a member of
the science working group for the James Webb telescope. Lunine has greatly contributed to the development of the telescope using it to continue investigating gas giants and their stars.
Lunine was part of the expansive team that helped develop the telescope starting in 2004. According to Lunine, developing the telescope required a large team of engineers to build the telescope, the science working group, leads on the telescope’s instruments and the project manage-
ment team. These worked together to greatly increase the telescope’s sensitivity to collect wavelength spectra.
Lunine’s research uses spacecraft data and mathematical modeling to understand the properties of the planets they are observing, including how the planet was formed and whether life could potentially exist there.
“I think there were many times when it just looked like this was an impossible engineering task and they pulled it off and it works tremendously well,” Lunine said. “It meets all the requirements and exceeds them.”
Because of Lunine’s work with the development of the Webb telescope, he was given guaranteed time observed: He and another colleague were able to have their targets of observation, which are all giant planets, identified before the telescope even launched.
Lunine is currently working on two main projects with the Webb telescope. The first project is to measure the composition of the atmospheres of “hot Jupiters” and “warm Jupiters” around other stars. This project focuses
on gathering data on the composition of these planets, which can range in size from Uranus to Jupiter.
To do this, they use the telescope to measure the spectrum of these planets, the distribution of light emitted from these planets as a function of wavelength or color. Molecules have their own spectral fingerprints, as there are distinct parts of the spectrum where they absorb radiation. Lunine and his team are mostly focused on determining how much carbon and oxygen are present in these atmospheres to understand how these materials were added to planets over time.
“But because [these planets] are so far away, they’re many, many light years or dozens of light years away, we can’t send spacecraft there,” Lunine said. “We need to have very, very sensitive telescopes to be able to see the very faint spectra that we can get of these extrasolar planets… that’s why we need the James Webb telescope.”
The second project observes very distant objects in our solar system known as Kuiper Belt objects. Scientists want to under-
stand the composition of the surface of these objects, as they are remnants of planet formation. Studying the Kuiper Belt Objects can provide a glance into the history of the solar system and give astronomers a chance to see what the building blocks of giant planets may have been like four and half billion years ago.
“This is kind of the graveyard of the stuff that didn’t make it into the giant planets and has been kind of left behind in orbit around the Sun for billions of years and far enough from the Sun that they remain cold,” Lunine said.
Lunine will be publishing several papers later this year utilizing the data gathered with the Webb telescope, and he is also looking forward to getting more time on the telescope and exploring more giant planets.
“This [the James Webb telescope] was really the most remarkable project,” Lunine said. “It was the most challenging, the most daring, the most nerve wracking of the projects.”
Cristina Torres can reached at ct538@cornell.edu
